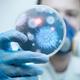
Los 5 descubrimientos medicos mas importantes de la historia 4

-
El primer médico conocido fue el egipcio Imhotep, quien alcanzó gran fama debido a sus curaciones.
-
En la India cirujanos efectúan amputaciones, injertos de piel y eliminación de cataratas en los ojos.
-
El médico italiano Sanctorius inventa el termómetro para tomar la temperatura del ser humano
-
El médico y fisiólogo inglés, William Harvey , dejó su huella en la historia al descubrir el "correcto funcionamiento de la sangre, porque hasta ese momento se pensaba que en las arterias sólo había aire"
-
El descubrimiento de los gérmenes ocurrió en el año 1676, cuando Anton van Leeuwenhoek, científico holandés,notó y describió por primera vez a las bacterias y los gérmenes. Si bien hubo varias personalidades de las ciencias que ya habían producido ciertos conceptos acerca de los gérmenes, nunca lograron la magnitud que el holandés alcanzó.
-
Leeuwnhoek mejora este instrumento y describe los globulos rojos y los capilares sanguíneos.
-
Edward Jenner, es en realidad el responsable del descubrimiento más importante en medicina: las vacunas. Jenner fue un gran médico inglés que descubrió la cura para la viruela, una enfermedad que hoy nos resulta lejana y de fácil prevención gracias a este hombre. La viruela es una infección altamente peligrosa, mortal y contagiosa que para el siglo XX se había cobrado 30 millones de muertes.
-
Ya a partir de la Edad Media se realizaron ciertos preparados capaces de adormecer algunos sentidos y demás, pero no fue hasta el siglo XIX que las primeras formas de anestesia real comenzaron a emplearse. Hasta entonces, todo era muy, pero muy diferente.
-
os pacientes que acudían a un hospital, hasta bien entrado el siglo XIX, tenían sólo un 50% de posibilidades de salir con vida.Los cirujanos no se lavaban las manos de un paciente a otro y creían que las enfermedades eran transmitidas por el aire. Lister describió que al lavar las heridas con el ácido se destruían los "gérmenes sépticos".
-
Anuncia el médico cubano Carlos J. Finlay que la fiebre amarilla se transmite por el mosquito denominado Culex o Aedes Aegypti.
-
El físico Wilhelm Conrad Röntgen descrubio los rayos x en 1895.
Determinó que estos rayos tenían una radiación muy penetrante, pero invisible, que traspasa grandes espesores de papel e incluso de hierro. Realizó la primera radiografía humana usando la mano de su mujer. Los llamó radios incógnita o radios X -
Aplican la primera inyección de insulina a un joven de 14 años.
-
Fue uno de los descubrimientos accidentales más sorprendentes. Fue descubierta por Alexander Fleming, quien mientras se encontraba estudiando la gripe en el año 1928, dejó una ventana del laboratorio abierta y se ausentó por casi un mes. Al volver al laboratorio descubrió que en la placa de petri que había olvidado, una especie de hongo había arruinado el cultivo de bacterias de estafilococo que allí guardaba.
-
Primer trasplante de riñón, realizado en Chicago, Estados Unidos.
-
Primer marcapasos y primera máquina auxiliar cardiorespiratoria.
-
Logra éxito la pastilla anticonceptiva para la mujer y su uso se generaliza a principios de 1960
-
El cirujano sudafricano Christian Barnard practica el primer trasplante de corazón. El paciente sobrevive 18 días.
-
El primer embarazo y nacimiento, originado mediante fecundación in vitro fue logrado por Steptoe y Robert G. Edwards en 1976, y resultó en el nacimiento de Louise Brown el 25 de julio de 1978 en Oldeham and District General Hospital de Láncashire, cerca de Mánchester (Reino Unido)
Plan projects on a visual timeline
Map milestones, phases, deadlines, and key events in one place so the sequence is easier to see and share. Timetoast is a timeline maker for work, school, research, and stories.